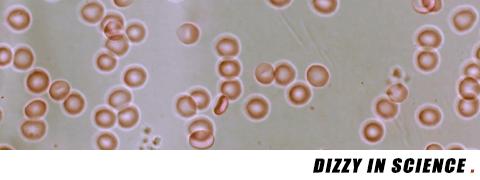
很血腥猎奇的三部纪录片,比较血腥的纪录片
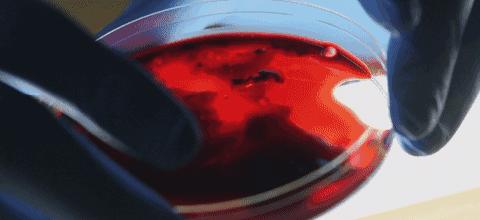
很血腥猎奇的三部纪录片,比较血腥的纪录片

我曾听过不少重口味的怪异食物。最早听闻用从自己阴道菌群中提取出乳酸菌做酸奶,最初非常诧异,但与朋友分享了数次之后,已经不会有任何不适了。
后来又听闻有人为了报复或者恶作剧,用自己周期性排出的血液做了血旺给男友吃。虽然恶心坏了,但我也立马在心底发起了质疑,每月分次排出且总量50ml左右的血真的可能完成吗?

答案大概是否定的,不过用自己的血做菜其实还是可行的。我以为没人会做那么无聊和自虐的事,直到看了这部纪录片——《血的奇妙世界》。
主持人迈克尔·莫斯利(在我们往期推荐的《食物的秘密》中出现过)就亲自下厨用自己300ml的血做了一道英国美味“黑布丁”。

当然莫斯利博士并不无聊也不爱自虐,他只是想证明血液是一种自然界中少有的高级营养食物。
我想很多人光是想象到血液从自己的身体里流出的场景,就会有一种莫名的手脚发软。也许这是一种生存策略,对自己血液产生恐惧感可以让人更加小心谨慎,尤其是那些容易受伤的行为。

这也说明了血液对人体的重要性。
为了展示这种重要性,莫斯利博士做了大牺牲贡献出自己500ml的新鲜血液(其中300ml都拿来做菜了)给节目研究。

血液最广为人知的作用就是输送氧气,陈词滥调也不再赘述了。但是,这一部分内容却牵扯到和兴奋剂相关的秘密。
人体通过血液给组织细胞输送氧气,但血液的携氧能力有上限,这个上限往往才是限制一个人运动能力的瓶颈。

当你力竭时,有可能不是肌肉太弱也不是心肺功能不强,而是血液不能够满足肌肉的消耗。想要突破这个瓶颈就要从血液的最大摄氧量上入手了。
人体可以分泌一种促红细胞生成素(EPO)的物质,能够刺激生成更多的红细胞,但这种激素的水平并不容易改变,一种可行的办法是置身于长期缺氧的环境中。

莫斯利在一个含氧量仅12%的空间中度过4小时之后,他体内的促红细胞生成素水平就提高了40%。而这种环境其实就是高原,很多耐力运动员偏爱赛前到高原集训就是这个原因。
当然被成绩蒙蔽了双眼的运动员甚至会直接注射外源性EPO,在几年前这还是一种非常前沿的作弊手段。
不过最近有研究认为注射EPO对运动员的运动水平几乎没有提高,所以那些因EPO而被处罚的运动员真的可能衰到家了。

除了能够携带氧气之外,血液中还含有非常多种物质,因此某些疾病可以通过验血来诊断。莫斯利博士为了证明血液中的成分杂而多变,亲自做了一个简单的实验。
他先后两天食用了油腻早餐和以蔬果谷物为主的清淡早餐,并在进食后抽取血液进行对比检测。结果很有意思,两份血液样品除了营养素含量的差别之外,研究员还找到了一个有意思的结果。

莫斯利吃了下了油腻早餐后,血液里出现了更多的前列腺素。前列腺素听起来像是什么男性专属的物质,实际上它和催产素一样,都是男女体内广泛存在的物质,只是最早发现于精液当中,所以安上了一个这样奇怪的名字。
前列腺素是一种不饱和脂肪酸,具有多种作用。其中一个与血非常相关,女性经期有可能会分泌大量前列腺素导致子宫平滑肌过度收缩,引起疼痛,这时吃可抑制前列腺素合成的非甾体抗炎药(常见的有阿司匹林和布洛芬)来缓解。

当然莫斯利博士血液里的前列腺素不是用来收缩平滑肌的,而是与炎症的发生有关。这种并非由损伤和感染引起的炎症反应很像我们中国民间所描述的“上火”。
经过我的简单查证,确实发现“广东凉茶”中含有的黄酮类和三萜皂苷类成分的确可以抑制炎症(王老吉加多宝等饮料中含量较低)。
也就是说,吃煎炸油腻食物真的会“上火”,“凉茶”真的能“下火”,也算是小小地破了一个案。

甘草苷、柚皮苷、槲皮素均为黄酮类物质
当然,血液中不仅仅有一些恼人的成分,更多的是滋养全身细胞的营养物质。自然界中有很多生物靠吸血就足矣生存。
为了验证血液营养丰富,莫斯利说几乎说有国家都有以血液为原料烹饪的菜式,说着说着就要下厨一展大英帝国的烹饪技法,文章开头提到的重头戏开始了。


黑布丁是英国名菜,虽然叫布丁,但和布丁真没什么关系,说白了就是一种混了猪牛羊下水和洋葱的血肠,颜色暗淡,结合它的外形,确实非常容易让人谈论起食欲的问题。

莫里斯手里拿着用自己的新鲜血液做成的黑布丁,一边说血液非常有营养,含有丰富的蛋白质、维他命C、铁元素,一边将锅子烧热。画面看起来总容易让人想起点不太美好的事物。

既然已经放血做菜了,那也必须聊一聊中世纪古方放血疗法了。放血疗法起初所治疗说起来和“上火”有些类似。炎症是人体的一种防御手段,通常的症状是增加血流、发热、红肿、疼痛。
人们认为这是血液过热过多造成的,于是就自然会想要通过放血来治疗。当然放血对某些病症还是有效的,但狂热地认为放血治百病肯定是愚昧的。

网上曾经流传过一些关于生气会在血液中产生有毒物质的说法。说法的真伪我们不论,但一些环境的变化的确会立马引起血液的改变。
莫斯利在冷水中进行了10分钟的皮划艇运动,血液中的自然*伤杀**细胞数量增加了一倍。这是寒冷和心理压力让身体认为将有可能出现损伤的表现,一旦发生损伤,自然*伤杀**细胞就能够及时处理。

如果真的出现外伤,抵抗感染还并不是最重要的,最重要的应当是止血。我们的血液里有细胞赖以生存的氧气和养分,每一滴都是珍贵的资源。因此,我们的血液还需要有自行止损的能力。
这一重任实际上落在了一种非常不起眼的血细胞上——血小板,当然现在也有人喜欢叫它老婆。血小板在血管发生损伤时能受激变形并聚集,同时促使血浆内的纤维蛋白原形成纤维蛋白,最终形成血栓阻止出血。

这一过程对几乎所有动物都至关重要。但也有一些暴徒试图利用这种过程来杀戮。有一些毒蛇的蛇毒就能模拟血管损伤时的状态,引发大规模的凝血反应,从而杀死猎物。
只需要非常少量的蛇毒,就能让大量的血液凝结,看起来就像是一块真正的血布丁。
血液的故事还有许多,从愚昧年代的血祭,认为吸血能同时吸取人的精力,到现代客观地看待,却发现一些关于血液的传说也并非毫无道理。
通过换血变得年轻并非完全不可能,血液中更有活力的干细胞也许是一个突破口。净化血液也的确能缓解诸如尿毒症这样的代谢疾病。

从不了解到了解,再到不了解,这是一种螺旋上升,血液中的秘密也许还会有更多。
作为一名热血青年,不吃下这一发血淋淋的纪录片安利,也许会血亏。